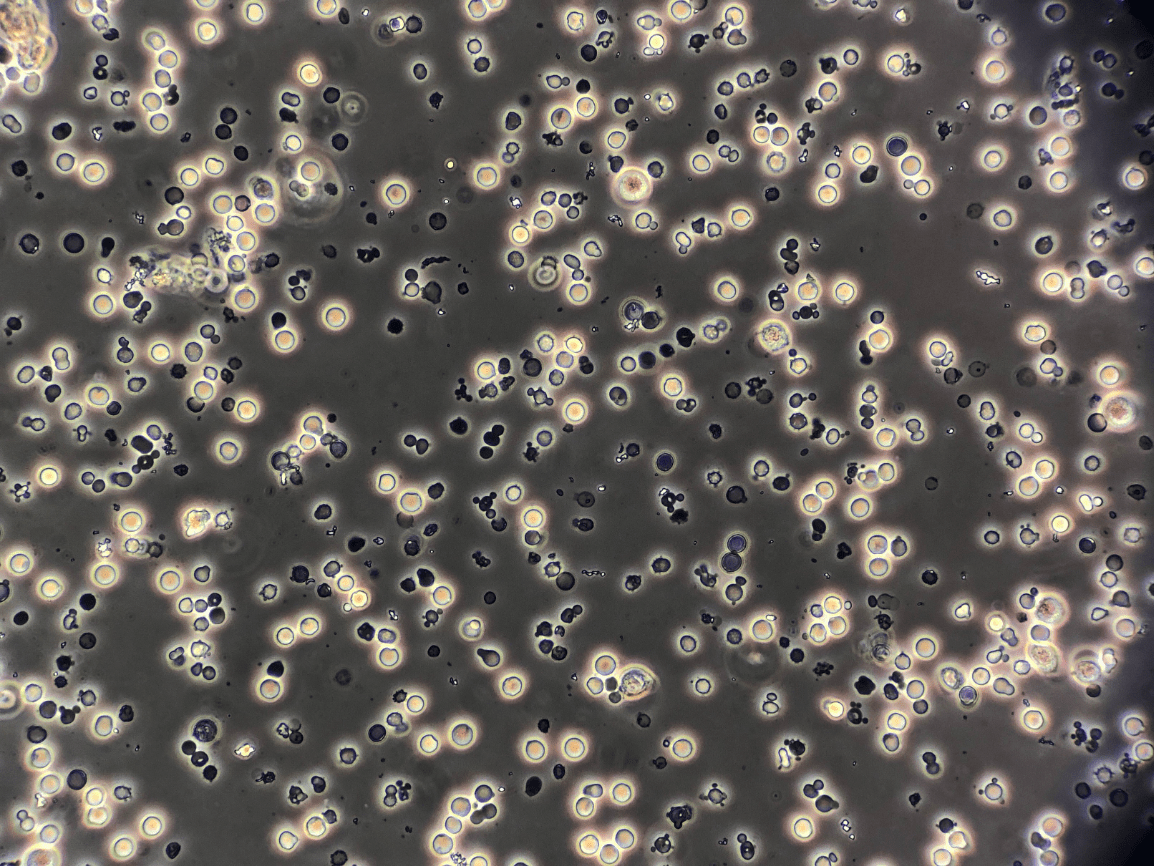

Diuretic that causes decreased blood pH and hypokalemia
What is acetazolamide? (will accept CA-inhibitors)
This medication antagonizes ADH receptors in the collecting duct and is used to slow cyst growth in ADPKD
What is Tolvaptan?
This class of medications is associated with significant renal and cardiac benefits but can increase the risk of urinary tract infections
What are SGLT2 inhibitors?
This finding on urine microscopy is indicative of glomerulonephritis
What are dysmorphic RBCs? (Will accept acanthocytes)
This peptide hormone is elevated in CKD and contributes to functional iron deficiency.
What is hepcidin?
This potentially fatal complication can happen if severe hyponatremia is corrected too rapidly
What is osmotic demyelination? (Will accept central pontine myelinolysis)
Increased GFR leads to increased proximal tubule reabsorption because THIS increases in peritubular capillary blood.
What is Oncotic pressure? (will accept colloid osmotic pressure)
This class of antiglycemic agents, developed from Gila monster venom, is useful both for prevention and treatment of diabetic kidney disease
What are GLP1-receptor antagonists?
The classic threshold for diagnosing asymptomatic bacteriuria in a voided urine sample (in CFU/mL)
What is >100,000 CFU/mL?
THIS glomerular disease can be caused by Hepatitis B, C, syphilis or lupus

What is Membranous Nephropathy?
This medication class suppresses PTH by stimulating calcium-sensing receptors on parathyroid glands
What are Calcimimetics?
Treatment for a patient with hyponatremia, volume overload, Urine Na <20 and Urine Osm >300
What are loop diuretics?
This peptide hormone causes increased PGC, increased filtration fraction, and decreased RPF
What is Angiotensin II?
This antibiotic can be used both for cystitis and pyelonephritis if there is no resistance, but can cause hyperkalemia
What is trimethoprim-sulfamethoxazole?
Urine dipstick picks up only THIS protein

What is albumin?
In Post-Streptococcal Glomerulonephritis, IF demonstrates lumpy-bumpy capillary loop staining for IgG and THIS immune factor

What is C3?
This is the most reliable volume status marker in metabolic alkalosis
What is urine chloride?
THIS is the cause of hyponatremia in a marathon runner who collapses at the finish, with Na 118 and urine Osm 80
What is psychogenic polydipsia?
Hyperkalemia causes Type IV RTA by inhibiting this enzyme
What is glutaminase?
This mixed alpha and beta blocker can be used to treat hypertension in patients with cocaine use disorder
What is labetalol?
This is the most likely pathogen to cause cystitis in a young woman with urine dipstick positive for leukocyte esterase but negative for nitrites.
What is Staph saprophyticus?
This immune compex-mediated glomerulonephritis can be associated with Hepatitis C, cryoglobulinemia and lupus and is recognized by subendothelial deposits and mesangial interposition into GBM
What is MPGN?
This type of CAKUT is characterized by a distended bladder on prenatal ultrasound

What is Posterior Urethral Valve?
Impaired diluting capacity in this nephron segment is to blame for thiazide‑induced hyponatremia
What is early distal convoluted tubule? (will accept distal convoluted tubule)
Nephron site where TF/Posm < 1.0 and PTH increases Ca2+ reabsorption
What is Early Distal Tubule?
This cell-cycle inhibitor used in kidney transplantation can cause severe cytopenias in combination with allopurinol
What is azathioprine?
This oral antibiotic has excellent tissue penetration in pyelonephritis, but should be avoided in pregnancy based on animal toxicity data
What is Ciprofloxacin?
(will accept oral fluoroquinolones)
This category of glomerulonephritis is characterized by proliferation of parietal epithelial cells in response to rupture of capillary loops
What is RPGN? (Will accept crescentic GN)
A person with a primary metabolic alkalosis and a PCO2 of 40 mm Hg also has this disorder
What is respiratory alkalosis?
A patient with hypovolemic hyponatremia will have THIS urine osmolarity in response to appropriate treatment
What is <200 mOsm/L? (Will accept dilute)
This medication, used for immunosuppression in transplantation, blocks calcineurin pathway of T cell activation via FK-binding protein.
What is tacrolimus?